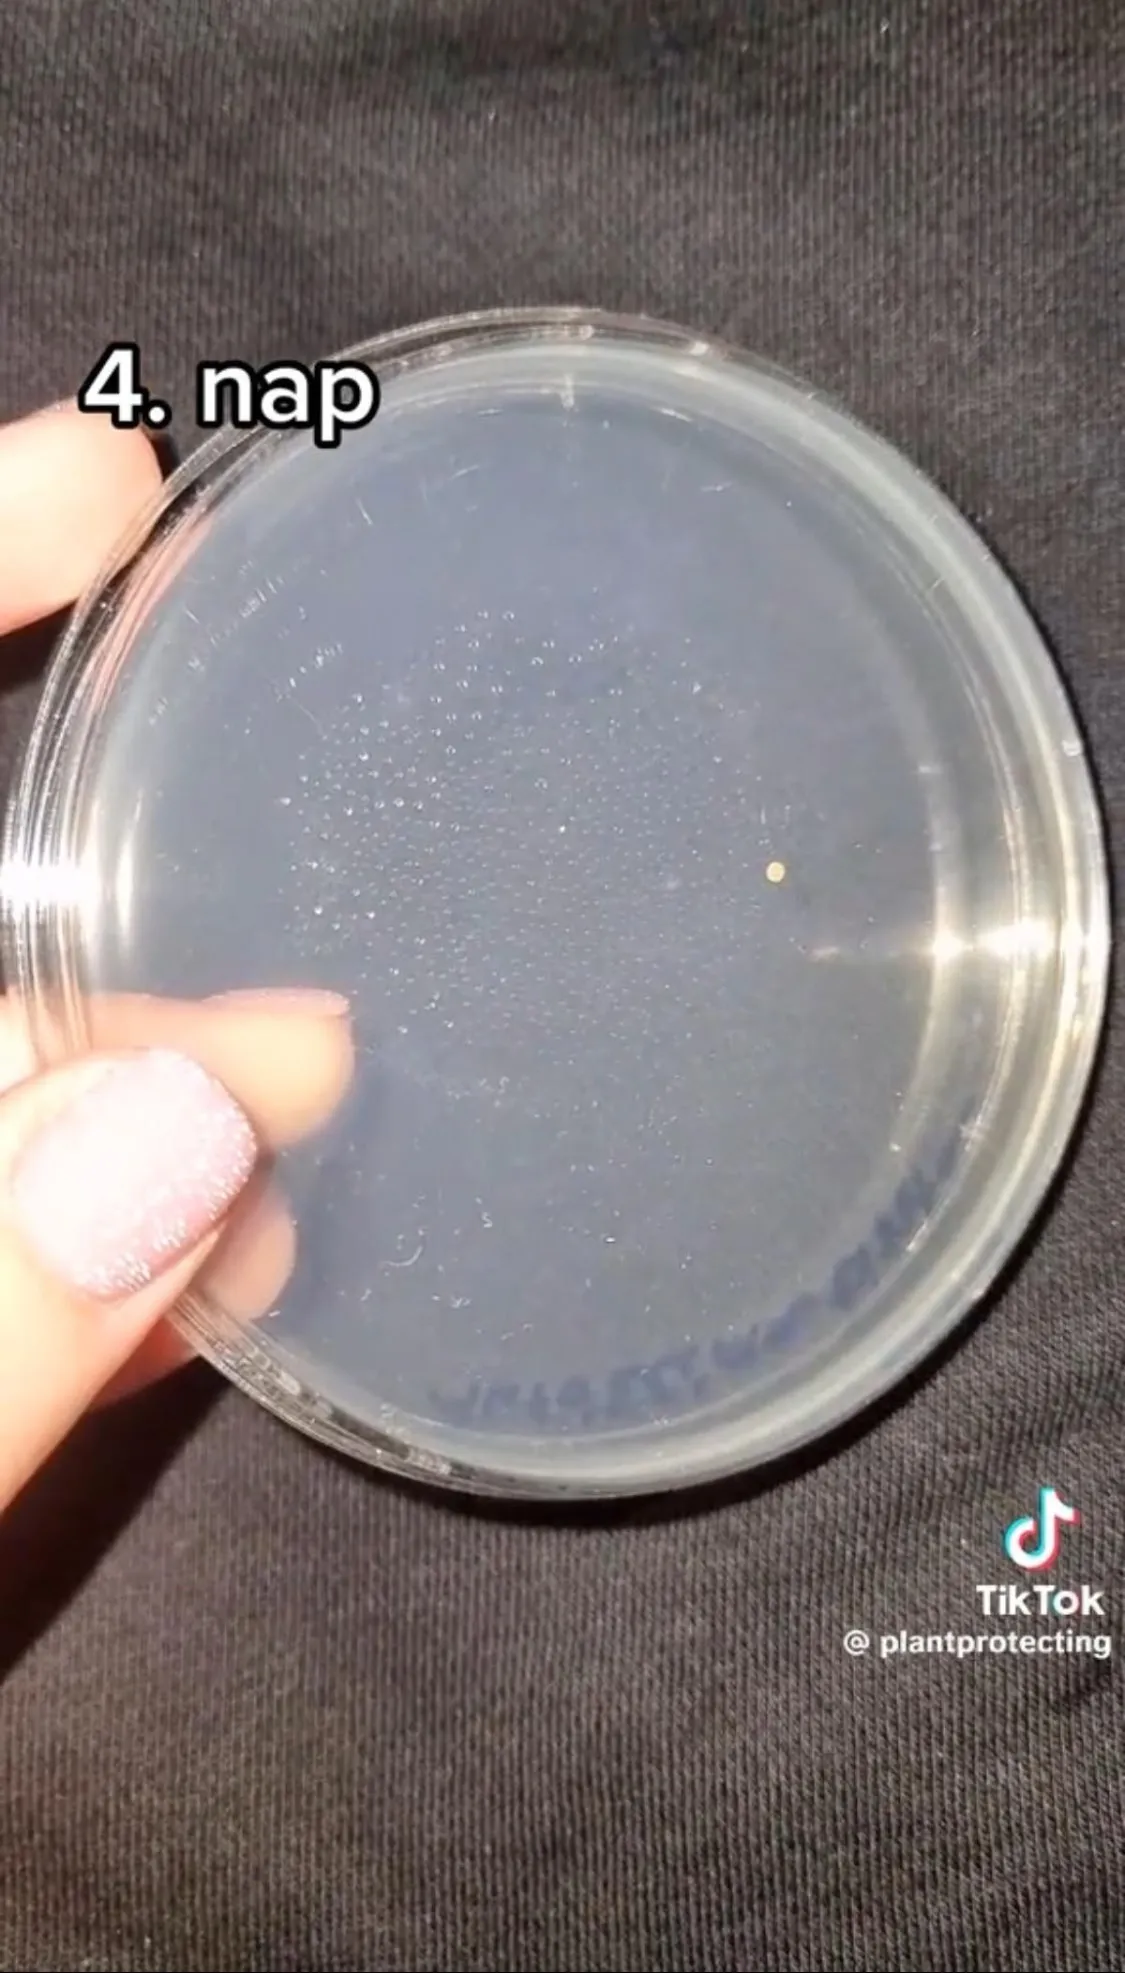

A szakember letesztelte egy autó klímáját, undorító, amit talált - ezért fontos, hogy ki legyen tisztítva!
A klíma jóleső hűvöst nyújt a nagy melegben, azonban fontos, hogy megfelelően karban legyen tartva. A TikTok növényorvosa, Gyuris Rita szemléltette, hogy miért fontos takarítani a kocsi klímáját is.
Gyuris Rita, a TikTok kedvenc növényorvosa rendszeresen mutatja meg az embereknek, hogy milyen baktériumok és gombák veszik körül őket. Most a klíma tisztításának fontosságát szemléltette.

„Jöjjön egy autóklíma fertőtlenítés előtt és után” - kezdte TikTok-videójában Rita.
Bármiféle takarítás nélkül mintát vettem a klímából kiáramló levegőből
- tette hozzá Rita, aki fertőtlenítés után is vett mintát.

A szakember folyamatában beszélt a kísérletről:
Első nap a koszos klímából vett mintán még nem nőtt fel semmi és a tiszta klímán sem. Második nap a koszos klíma mintáján megjelent egy gombatelep és kezdett növekedni, mellette még nagyon-nagyon apró baktérium kolóniákat fedeztem fel. A tiszta klímából vett mintán második napon sem látok egyenlőre semmit. A koszos klíma mintáján harmadik napra elkezdtek felnőni a gombák, egyre többféle, egyre nagyobbak lesznek. A tiszta klíma mintájára harmadik napra egy nagyon apró baktérium kolónia ütötte fel a fejét, mást nem látok. A koszos klímánál negyedik napra növekednek a gombák, egyik olyan mélyre nőtt, hogy kirepesztette a táptalajt. Különböző formákat öltenek, többféle gomba és baktérium van rajta. A tiszta klímánál negyedik napra növekszik az egy baktériumkolónia, meg még egy felütötte a fejét
- magyarázta a növényorvos.
Íme az utó klímateszt videón:






